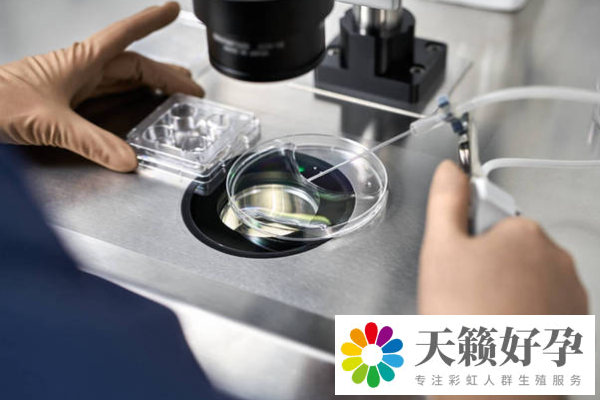
第三代試管嬰兒成功率高不高

第三代試管嬰兒成功率高嗎,第三代試管嬰兒能篩查遺傳病嗎
隨著醫學技術的不斷進步,試管嬰兒技術逐漸成為越來越多家庭的選擇。尤其是第三代試管嬰兒,由於其在胚胎篩查方面的優勢,成為了不孕不育治療中備受關注的方法。那么,第三代試管嬰兒成功率高嗎,第三代試管嬰兒能篩查遺傳病嗎?我們知道,第三代試管嬰兒能通過胚胎植入前遺傳學篩查技術,有效地排除一些遺傳性疾病的風險,幫助家庭避免遺傳性疾病的發生。
第三代試管嬰兒對年齡有要求嗎?
試管嬰兒,即“體外受精-胚胎移植”,要求女性在進行該治療前,身體狀況良好,尤其需要年齡、內分泌、子宮內膜等方面符合標準。若有內分泌失調或子宮內膜異常,需先進行治療,恢復后再行操作,否則可能影響成功率。
最佳的受孕年齡為24-35歲,年齡過大可能導致生育能力下降,成功率降低。內分泌紊亂可能影響胚胎著床,增加流產風險。而子宮內膜損傷、炎癥或疾病(如子宮腺肌癥、內膜息肉)也會降低移植成功率。
第三代體外受精-胚胎移植技術通過對胚胎DNA分析,篩選健康胚胎,避免遺傳病和其他異常。若胚胎未發現異常,且女性身體狀況正常,通常1-2次操作即可成功著床。在治療期間,保持愉快心情和適度鍛煉,有助于提高成功率。

第三代試管嬰兒成功率高不高?
第三代試管嬰兒的成功率一般在40%至60%之間,受多種因素影響。首先,女性年齡是決定性因素,年輕女性卵巢功能較好,卵子質量更佳,成功率較高;隨著年齡增大,成功率逐漸下降。
胚胎質量也是關鍵,優質胚胎更容易著床和發育。生殖中心的技術水準、設備條件、醫療團隊經驗以及患者的身體狀況(如子宮內膜厚度和有無其他疾病)都會影響成功率。
為了提高成功率,患者應配合醫生進行全面檢查,制定個性化治療方案。同時,保持良好心態,避免焦慮,遵循醫生建議,注意飲食、運動和作息等生活細節,保持身體健康。
選擇正規、專業的生殖中心也非常重要,先進技術和經驗豐富的團隊能夠提升成功的機會。儘管成功率不能保證為100%,但通過雙方的共同努力,成功幾率會顯著提高。
第三代試管嬰兒可以篩查遺傳病嗎?
第三代試管嬰兒技術通過體外受精后對胚胎進行基因檢測,能夠有效篩查和避免攜帶遺傳缺陷的胚胎,從而降低胎停育、流產等風險。盡管此技術能有效排除一些遺傳病,但無法完全杜絕遺傳病的發生。
通過基因檢測,第三代試管嬰兒可以篩查常見的遺傳病,包括常染色體顯性和隱性遺傳病、X連鎖遺傳病、染色體病、單基因遺傳病(如地中海貧血、血友病)和多基因遺傳病(如精神分裂癥、重癥先天性心臟病等)。
盡管如此,第三代試管嬰兒技術仍無法完全避免所有類型的遺傳疾病,特別是一些複雜的遺傳問題可能依然存在。因此,儘管該技術大大提高了避免遺傳疾病的可能性,但仍無法做到百分之百的保障。
第三代試管嬰兒胚胎如何保存?
第三代試管嬰兒胚胎保存是將多余的受精卵或初期胚胎通過低溫保存,從而延長胚胎保存時間并提高移植成功率。常見的保存方法有兩種:液氮保存和快速保存。
液氮保存是將受精卵或胚胎浸入含保護劑的液氮中,達到極低溫度。這種方式能夠有效保護細胞和組織,防止低溫對其造成損傷。
快速保存則是將胚胎迅速冷卻至極低溫,避免結晶形成和水分凝固,從而更好地保留細胞和組織的完整性。這兩種方法都有助於提高胚胎存活率,並確保胚胎在需要時能成功移植。





